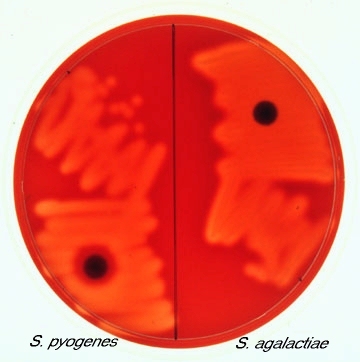

Hemólisis
Streptococcus
- Beta (completa), excepto S.viridans y S. pneumoniae (alfa)
- Transparente
Clasificación serológica (Lancefield)
Grupo A y B
Streptococcus
A: GAS - S. pyogenes
B: GAB - S. agalactiae
Optoquina
Difusión en disco: sensible y resistente
Streptococcus
Sensible: S. pneumoniae
Resistente: S. viridans

Bacitracina
Difusión en disco: sensible y resistente
Streptococcus
Sensible: S. pyogenes
Resistente: S. agalactiae
Gram de streptococcus
Gram +
Morfología de streptococcus
- Cocos
- Pares (diplococos) o cadenas cortas
Metabolismo de streptococos
Anaerobios facultativos
Catalasa +/-
Streptococos
Catalasa -
Fermentación de streptococos
Fermentadores productores de ácido láctico
Géneros de Streptococcus
Vistos en clase
- S. pyogenes
- S. agalactiae
- S. viridans
- S. pneumoniae
Factores de virulencia
S. pyogenes
- Antígeno A: N-acetilglucosamina/ramnosa en pared celular
- Proteína M: estructural a virulencia, variantes determinan serotipos
- Cápsula: causa infecciones sistémicas graves
Evasión de respuesta inmune
S. pyogenes
- Cápsula de ác. hialurónico
- Proteína M: evita fagocitosis
- Proteína F (y M): adherencia e invasión a epitelios
- Peptidasa C5a: evita quimiotaxis de fagocitos
Toxinas (superantígenos de la misma familia de toxinas estafilocócicas)
S. pyogenes
Spe: exotoxinas pirógenas estreptocócicas
- SpeA, B, C, F
Invasinas
S. pyogenes
- Estreptolisina S: hemolisina no inmune, b-hemólisis
- Estreptolisina O: inmune –> anti-ASO
- Estreptocinasas: lisan coágulos y fibrina
- ADNasas: reduce viscosidad de abscesos
Enfermedad por invasión
S. pyogenes
Faringitis estreptocócica
Enfermedades por toxinas
S. pyogenes
- Escarlatina: exotoxinas
- Síndrome de Shock Tóxico Estreptocócico: SpeA, C
Enfermedades cutáneas
S. pyogenes
- Impétigo
- Celulitits
- Erisipelas
- Fascitis necrosante
Mediadas por invasinas
Enfermedades mediadas por propios anticuerpos
S. pyogenes
- Fiebre reumática
- Glomerulonefritis aguda
Faringitis estreptocócica
S. pyogenes
- Por invasión
- Faringe enrojecida con exudados/abscesos
- Se complica cuando migra de la faringe
Escarlatina
S. pyogenes
- Por toxinas: exotoxinas
- Piel en lija: exantema eritematoso difuso, comienza en tórax
- Triángulo de Filatov (nariz a ángulos de barbilla)
- Lengua de fresa
- Líneas de Passia (pliegues anticubitales rojos)
Síndrome de Shock Tóxico Estreptocócico
S. pyogenes
- Por toxinas: speA, C
- Infección sistémica multiorgánica: fiebre, escalofríos, náusea, vómito, diarrea
- Cepas M1 y M3, mucoides
- Inflamación de tejidos blandos
Impétigo
S. pyogenes
- Por invasinas
- Igual a Staph. aureus
- Costras amarillas
Celulitis
S. pyogenes
- Por invasinas
- Bordes difusos
Erisipela
S. pyogenes
- Por invasinas
- Única de Strep.
- Infección cutánea dolorosa con bordes definidos
- Hipertrofia de ganglios y síntomas sistémicos
- Más superficial que celulitis


